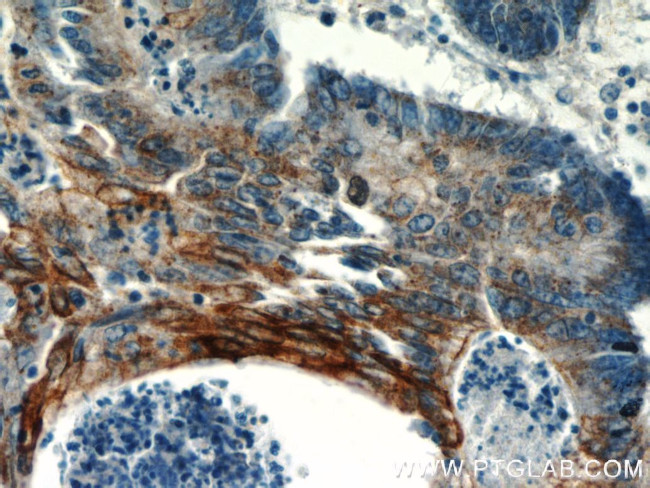
TMEM9B Antibody in Immunohistochemistry (Paraffin) (IHC (P))
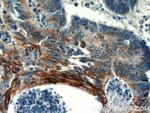
TMEM9B Antibody in Immunohistochemistry (Paraffin) (IHC (P))

Search
Proteintech
TMEM9B Polyclonal Antibody
{{$productOrderCtrl.translations['antibody.pdp.commerceCard.promotion.promotions']}}
{{$productOrderCtrl.translations['antibody.pdp.commerceCard.promotion.viewpromo']}}
{{$productOrderCtrl.translations['antibody.pdp.commerceCard.promotion.promocode']}}: {{promo.promoCode}} {{promo.promoTitle}} {{promo.promoDescription}}. {{$productOrderCtrl.translations['antibody.pdp.commerceCard.promotion.learnmore']}}
产品信息
24331-1-AP
种属反应
宿主/亚型
分类
类型
抗原
偶联物
形式
浓度
规格
纯化类型
保存液
内含物
保存条件
运输条件
产品详细信息
Immunogen sequence: PDVEAYCLR CECKYEERSS VTIKVTIIIY LSILGLLLLY MVYLTLVEPI LKRRLFGHAQ LIQSDDDIGD HQPFANAHDV LARSRSRANV LNKV (80-172 aa encoded by BC040124)
靶标信息
TMEM9B, also termed as Transmembrane protein 9B encodes a 198 amino-acid protein that contains an N-terminal signal peptide, a single transmembrane region, three potential N-glycosylation sites, and three conserved cys-rich domains in the N-terminus. There is a dimer form of TMEM9B protein. TMEM9B mRNA is expressed in a wide range of tissues and cells. TMEM9B is a lysosomal transmembrane protein that regulates the activity of inflammatory signaling pathways.
仅用于科研。不用于诊断过程。未经明确授权不得转售。
篇参考文献 (0)
生物信息学
蛋白别名: ICRFP703N2430Q5.3; Transmembrane protein 9B; unnamed protein product
基因别名: 2310004K06Rik; AW539847; C11orf15; D7H11orf15; ICRFP703B1614Q5.3; RGD1310775; TMEM9B; UNQ712/PRO1375
UniProt ID: (Human) Q9NQ34, (Mouse) Q9JJR8
Entrez Gene ID: (Human) 56674, (Mouse) 56786, (Rat) 293415